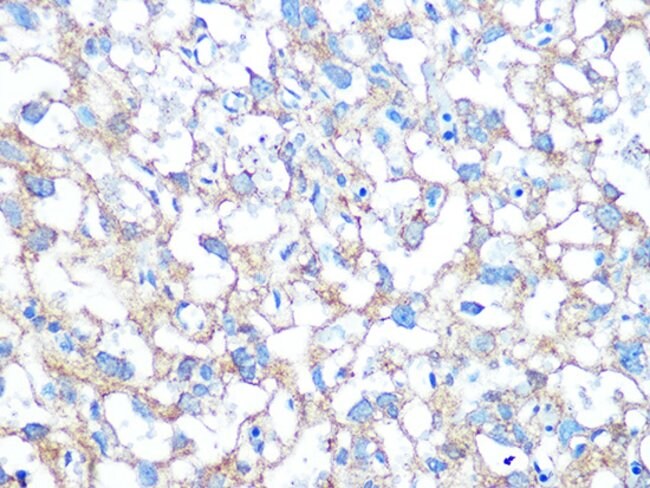

PLAP Antibody (Immunohistochemistry)
The PLAP (Placental Alkaline Phosphatase) Antibody is an important IHC marker.
It helps identify germ cell tumors and related neoplasms with high diagnostic value.
In addition, PLAP is an alkaline phosphatase isoenzyme produced in placental syncytiotrophoblasts
and primordial germ cells.
Moreover, PLAP positivity commonly appears in Seminoma,
Embryonal Carcinoma, and Placental Site Trophoblastic Tumors.
As a result, its membrane or cytoplasmic staining pattern becomes a strong indicator of germ cell origin.
Therefore, PLAP plays a key role in tumor classification and differential diagnosis.
🔬 Features and Benefits
- Specific marker for germ cell tumors
- Clear brown membrane or cytoplasmic staining in positive cells
- Highly useful for seminoma and embryonal carcinoma diagnosis
- Compatible with standard IHC diagnostic workflows
- Stable for up to 18 months at 2–8 °C
💡 Diagnostic Applications
- Detection of Seminoma and Embryonal Carcinoma
- Identification of placental and germ cell tumors
- Differentiation from non–germ cell metastatic tumors
- Research involving alkaline phosphatase expression in neoplasms
🌐 Fardad Azma Rad Co.
Fardad Azma Rad Co., the exclusive representative of
Talent Biomedical in Iran, supplies high-quality IHC antibodies, including PLAP.
Furthermore, the company focuses on accuracy, quality, and international diagnostic standards.
As a result, pathology laboratories and cancer research centers across Iran receive reliable and professional support.
There are no reviews yet.